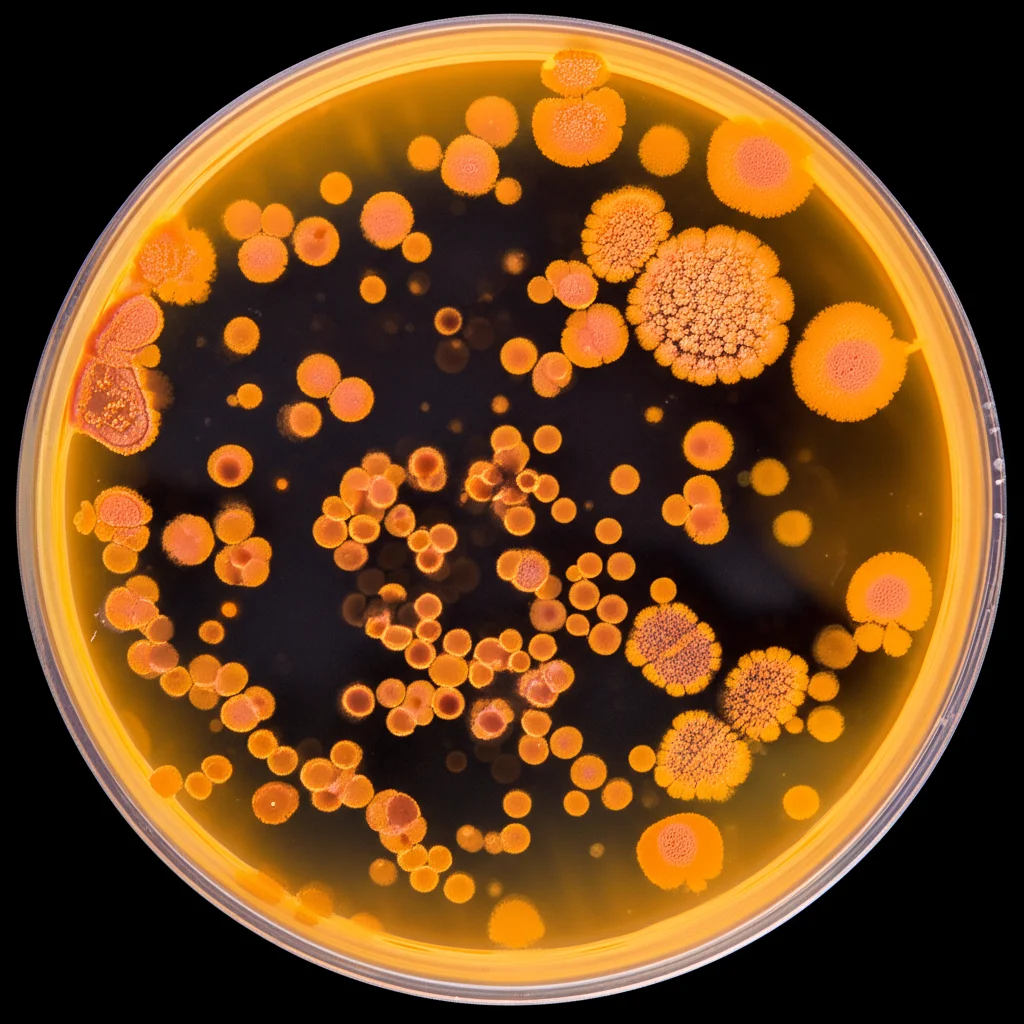
Lenti macro, 105 mm, dettagli elevati, illuminazione controllata, una piastra di Petri che mostra vibranti colonie rossastre-arancione del lievito di rodoturula toruloides, con alcune cellule ingrandita per rivelare piccole e luccicanti gocce lipidiche al suo interno, su un background sterile di laboratorio.

Rhodotorula toruloides: Il Lievito “Mangiaplastica” che Trasforma l’Etilenglicole in Oro Cosmetico!
Amici appassionati di scienza e soluzioni green, tenetevi forte! Oggi voglio parlarvi di una scoperta che mi ha letteralmente entusiasmato e che potrebbe aprire scenari incredibili per il futuro del riciclo della plastica e la produzione di composti di valore. Immaginate un microrganismo, un lievito per la precisione, capace non solo di “digerire” uno dei componenti della plastica PET, ma anche di trasformarlo in una sostanza preziosa per l’industria cosmetica. Sembra fantascienza? Beh, preparatevi a conoscere il protagonista di questa storia: Rhodotorula toruloides, un lievito oleaginoso che si sta rivelando una vera e propria superstar nel campo delle bioraffinerie.
Il Problema PET e l’Etilenglicole: Un Rifiuto da Valorizzare
Partiamo dal principio. Il polietilene tereftalato (PET) lo conoscete tutti: è quella plastica onnipresente nelle bottiglie delle bevande, negli imballaggi alimentari e persino nei teli agricoli. La sua domanda è in continua crescita, ma purtroppo i tassi di riciclo, specialmente per i film multistrato (quelli che combinano plastica con carta, alluminio, ecc.), sono ancora bassissimi. Un vero peccato, perché il PET, se scomposto, rilascia due monomeri principali, e uno di questi è l’etilenglicole (EG). Fino ad ora, molti studi si sono concentrati sulla degradazione dell’EG da parte di batteri, ma il mondo dei lieviti, robusti e versatili “operai” microbiologici, era rimasto un po’ in ombra su questo fronte. Almeno fino ad ora!
L’idea che ci ha guidato nel nostro laboratorio era ambiziosa: e se potessimo prendere i residui del settore agroalimentare, inclusi questi monomeri plastici, e trasformarli in prodotti ad alto valore aggiunto? Ecco che i nostri occhi si sono puntati sull’EG e sulla capacità dei lieviti di farci qualcosa di buono.
Rhodotorula toruloides: Un Lievito dalle Mille Risorse
Perché proprio Rhodotorula toruloides? Beh, questo lievito è già una celebrità nel suo campo. È noto per la sua capacità di “banchettare” con diverse fonti di carbonio, inclusi gli zuccheri rilasciati dagli idrolizzati di emicellulosa (presenti negli scarti agricoli), e per la sua incredibile robustezza e tolleranza a composti inibitori. Ma la sua vera specialità è accumulare lipidi, oli, fino al 70% della sua biomassa! Una vera e propria fabbrica di grassi naturali. E, cosa ancora più intrigante per noi, studi preliminari avevano suggerito che R. toruloides potesse convertire l’EG in acido glicolico (GA). L’acido glicolico, per chi non lo sapesse, è un piccolo alfa-idrossiacido super utilizzato nell’industria cosmetica, con un mercato che si prevede raggiunga cifre da capogiro entro il 2030. Capite bene l’interesse!
Finora, però, mancava una caratterizzazione dettagliata di questo metabolismo, soprattutto in condizioni controllate e in presenza degli zuccheri più abbondanti negli scarti lignocellulosici, cioè glucosio e xilosio. Ed è qui che siamo entrati in gioco noi!
Le Nostre Scoperte: L’EG e il Glucosio, un’accoppiata Interessante
Abbiamo iniziato i nostri esperimenti coltivando R. toruloides in un terreno contenente glucosio, con e senza l’aggiunta di EG. Per stimolare la produzione di lipidi, abbiamo impostato un rapporto carbonio/azoto (C/N) di 80. Inizialmente, durante la fase di crescita esponenziale, il lievito sembrava ignorare l’EG, crescendo allo stesso modo in entrambi i casi. Ma poi, una volta che l’azoto nel terreno ha iniziato a scarseggiare (fase di limitazione di azoto o Nlim), ecco la magia: R. toruloides ha iniziato a consumare l’EG e a produrre acido glicolico! E con che resa! Praticamente il 98.83% dell’EG consumato è stato trasformato in GA.
C’era un piccolo intoppo: la produzione di GA abbassava il pH del terreno, rallentando un po’ la crescita e il consumo di glucosio. Ma ripetendo l’esperimento in bioreattori dove potevamo controllare il pH, abbiamo visto che le differenze di crescita sparivano. La cosa davvero sorprendente è che, in condizioni controllate, la presenza di EG e la conseguente produzione di GA non sembravano influenzare negativamente né la crescita specifica né la produzione di lipidi o proteine rispetto al controllo senza EG. Questo è un dato pazzesco! Significa che R. toruloides può produrre GA senza “distrarsi” dalla sua normale attività metabolica in presenza di glucosio.
E la resa di conversione EG in GA? Un incredibile 100% molare (1.01 ± 0.03 mol mol-1) durante il co-consumo di glucosio! Questo è un risultato notevole, perché in altri lieviti studiati le rese sono tipicamente inferiori. Sembra quasi che, almeno in presenza di glucosio, R. toruloides sia un cecchino infallibile nel trasformare EG in GA, senza disperdere risorse per ossidare ulteriormente il GA. Questo lo rende un candidato eccellente per una bioraffineria che punti alla produzione di GA da EG.
E con lo Xilosio? Ancora Più Sorprese!
Non contenti, abbiamo voluto vedere cosa succedeva mettendo R. toruloides alla prova con lo xilosio, il secondo zucchero più abbondante negli idrolizzati emicellulosici. E qui le cose si sono fatte ancora più intriganti! L’acido glicolico ha iniziato a comparire quasi subito, e il lievito ha co-consumato xilosio ed EG per tutta la durata della coltivazione. Ma la vera sorpresa è stata un’altra: durante la fase di crescita esponenziale, la velocità di crescita specifica massima era significativamente più alta in presenza di EG! Sembrava quasi che l’EG desse una marcia in più al lievito quando si trattava di metabolizzare lo xilosio. Anche il consumo di xilosio era quasi doppio in presenza di EG verso la fine della fase esponenziale.
Monitorando il pH e l’ossigeno disciolto in tempo reale, abbiamo confermato questo aumento della velocità di crescita. Ma c’è di più: durante la fase di limitazione di azoto, la resa di GA da EG era del 159.8 ± 20.4% molare! Aspetta un attimo… più del 100%? Come è possibile? Questo suggeriva che il GA non provenisse solo dalla conversione diretta dell’EG, ma che potesse esserci qualche altra reazione metabolica che contribuiva alla sua produzione. Non abbiamo mai osservato GA nei controlli senza EG, quindi l’etilenglicole era chiaramente il “grilletto”.
Svelare i Percorsi Metabolici: Ipotesi e Modelli
Per capirci qualcosa, ci siamo affidati alla modellazione metabolica su scala genomica (Flux Balance Analysis). I risultati hanno suggerito che, in presenza di xilosio ed EG, una parte del carbonio proveniente dallo xilosio potesse essere incanalata attraverso lo shunt del gliossilato (un percorso metabolico alternativo) verso la produzione di GA. In pratica, il gliossilato prodotto nel ciclo degli acidi tricarbossilici (TCA) verrebbe trasportato nel citosol e convertito in GA.
Ma perché l’EG migliora la crescita su xilosio? L’utilizzo dello xilosio da parte dei lieviti spesso crea uno squilibrio di cofattori (NADH/NADPH). L’ossidazione dell’EG ad acido glicolico, invece, genera due molecole di NAD(P)H per ogni molecola di EG. Questo potrebbe parzialmente alleviare lo squilibrio di cofattori, “spingendo” il catabolismo dello xilosio e spiegando la migliore forma fisica del ceppo in presenza di EG. Un’altra ipotesi affascinante è che un intermedio del metabolismo dello xilosio, il D-xilulosio, possa essere fosforilato e poi scisso per produrre, tra le altre cose, glicoaldeide (GAH), un precursore diretto del GA. Questo spiegherebbe le rese superiori al 100%.
E se diamo a R. toruloides solo EG come fonte di carbonio? Niente da fare, non cresce. Però, anche in queste condizioni, una piccola quantità di GA viene prodotta. Questo conferma che il lievito non usa l’EG per costruire biomassa, ma forse solo come fonte di energia o per rigenerare cofattori.

Glucosio, Xilosio ed EG: Un Trio Complesso
Abbiamo anche testato la capacità di R. toruloides di metabolizzare l’EG in presenza sia di glucosio che di xilosio, simulando un idrolizzato più realistico. Con un alto rapporto C/N (limitazione di azoto), il consumo di EG e la produzione di GA avvenivano durante il consumo di glucosio (dopo l’inizio della Nlim) e continuavano anche dopo l’esaurimento del glucosio, quando il lievito iniziava a consumare xilosio. Interessante, però, il comportamento con un basso rapporto C/N (senza limitazione di azoto): il consumo di EG e la produzione di GA non iniziavano finché c’era glucosio nel terreno, suggerendo un meccanismo di repressione catabolica da glucosio. Anche qui, le rese di GA da EG durante la carenza di azoto erano del 117% su glucosio e addirittura del 191% su xilosio!
Alla Ricerca dei Geni Responsabili
Una parte cruciale del nostro lavoro è stata cercare di identificare i geni di R. toruloides potenzialmente coinvolti nel metabolismo dell’EG. Abbiamo confrontato sequenze proteiche di geni batterici e di altri lieviti noti per essere coinvolti in queste reazioni con il genoma di R. toruloides. Per l’ossidazione dell’EG a glicoaldeide (GAH), i candidati più promettenti sembrano essere delle alcol deidrogenasi e delle idrossisteroidi deidrogenasi/isomerasi. Per la successiva ossidazione del GAH ad acido glicolico (GA), diverse aldeide deidrogenasi ad ampio spettro sembrano essere coinvolte.
Un mistero rimaneva: perché R. toruloides è così bravo a fermarsi al GA, senza ossidarlo ulteriormente a gliossilato (GOX)? La reazione è catalizzata dalla gliossilato reduttasi (Gor1). Abbiamo identificato alcuni geni candidati per Gor1 in R. toruloides, e dati precedenti indicano che sono espressi. Tuttavia, la sua attività nel convertire GA in GOX sembra essere silente o molto bassa nelle nostre condizioni. Questo comportamento sembra specifico di R. toruloides e contribuisce alla sua alta efficienza nella produzione di GA.
Il percorso che proponiamo (vedi Figura 6 dell’articolo originale) vede l’EG ossidato a GAH da alcol deidrogenasi e/o idrossisteroidi deidrogenasi/isomerasi, e poi il GAH ossidato a GA da aldeide deidrogenasi. Il ruolo di Gor1 rimane da chiarire, ma sembra favorire la formazione di GA o essere poco attivo verso la sua ossidazione.

Conclusioni e Prospettive Future: Un Lievito Pieno di Promesse
Cosa ci portiamo a casa da questo studio? Innanzitutto, abbiamo dimostrato che Rhodotorula toruloides è un candidato eccezionale per la produzione di acido glicolico a partire da etilenglicole. La sua capacità di raggiungere una resa del 100% in presenza di glucosio è straordinaria. Inoltre, la sua abilità nel co-consumare EG e xilosio, con un apparente miglioramento della crescita su xilosio, apre scenari interessantissimi per le bioraffinerie basate su emicellulosa. Immaginate di poter usare questo lievito per produrre contemporaneamente oli microbici da biomasse residuali e il prezioso acido glicolico da EG (magari derivante da rifiuti plastici), beneficiando al contempo di una migliore utilizzazione dello xilosio!
Certo, c’è ancora lavoro da fare. Bisognerà confermare i geni coinvolti, magari con tecniche di ingegneria metabolica, e ottimizzare i processi. Ma i risultati sono incredibilmente promettenti. R. toruloides potrebbe davvero aiutarci a chiudere il cerchio, trasformando rifiuti problematici come la plastica e gli scarti agricoli in prodotti utili e di valore, in un’ottica di economia circolare sempre più necessaria.
Per me, questa ricerca è la prova che la natura nasconde soluzioni geniali ai nostri problemi più pressanti. Basta saperle cercare e, con un po’ di ingegno, metterle al nostro servizio. E chissà quali altre sorprese ci riserverà il piccolo, ma potente, Rhodotorula toruloides!
Fonte: Springer







